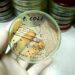
Da salmonella a listeria a E.Coli, ipotesi in campo in tossinfezioni alimentari

(Adnkronos) – Il ministero della Salute, ex-Direzione generale della Prevenzione sanitaria, ha posto l'attenzione sui numerosi energizzanti in polvere presenti sul mercato, reperibili anche online, "con simile composizione (in genere contengono sostanze come arginina, creatina, caffeina, L-citrullina, beta-alanina, taurina), presentati sotto forma di polvere bianca e con chiari messaggi ad assumerla per via inalatoria, anche quando si tratta di polvere da ricostituire. Sia le pubblicità sia le denominazioni suggeriscono fortemente l'assunzione per via inalatoria: i messaggi promozionali presenti sui social media ne incentivano l'utilizzo con messaggi fuorvianti indirizzati alle fasce più giovani, con possibili danni di salute ed assuefazione all'assunzione ingiustificata di stimolanti". Lo riporta il ministero della Salute sul proprio sito. "Considerata pertanto la presenza in vendita online (Amazon e altri siti) di diversi prodotti energizzanti con la denominazione generica 'sniff', presentati come polveri da assumere per via inalatoria, al fine di tutelare la salute pubblica, soprattutto delle fasce di età più suscettibili, e di proteggere la salute dei soggetti fragili, come le donne in gravidanza, la ex-Direzione generale della Prevenzione sanitaria, dopo specifica valutazione del rischio da parte dell'Istituto superiore di sanità ai sensi dell'articolo 107 del D.Lgs. n. 206/2005, ha inviato formale diffida alla vendita per tali prodotti". —salutewebinfo@adnkronos.com (Web Info)